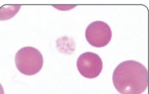

Erythrocytes
1/11
There's no tags or description
Looks like no tags are added yet.
Name | Mastery | Learn | Test | Matching | Spaced |
|---|
No study sessions yet.
12 Terms
What false biochemical results can ETDA contamination cause?
Hyperkalaemia
Hypocalcaemia
Low magnesium and zinc possible
What is the PCV % reference range for canine, feline, equine and bovine species?
Canine = 37-55
Feline = 30-45
Equine = 32-52
Bovine = 24-46
What can be assessed with a blood smear?
Check cell morphology
Check for infectious agents
Platelet count
Check WBC morphology

Name this poikilocyte. What causes it
Crenation/Echinocyte
Artefactual (old sample)

Name this poikilocyte. What causes it?
Acanthocyte
Dog cancer
Normal in calves

Name the poikilocyte being pointed at. What causes it.
Schistocyte
Caused by shearing injury to RBC
Common in haemangiosarcomas

Name the dark poikilocyte. What causes it?
Polychromatophil
immature RBC
What are the 3 poikilocytes in the middle called? What causes them?
Spherocyte
indicate membrane damage
seen in IMHA
What are the 2 types of haematopoiesis and where do they occur?
Erythropoiesis = formation of RBCs and platelets. occurs in bone marrow
Myelopoiesis = formation of leukocytes. bone marrow, lymph nodes, spleen (liver?)

What are these pale cells called and what causes them?
Hypochromatic cells
caused iron deficiency (chronic disease, inflammation, liver disease = non regenerative anaemia)
Gold standard test for investigating haematopoietic disorders?
Bone marrow biopsy
4 functions of the spleen
Lymphoid organ - filters antigens from the blood for processing
Blood reservoir
Metabolises iron
Removes damaged erythrocytes